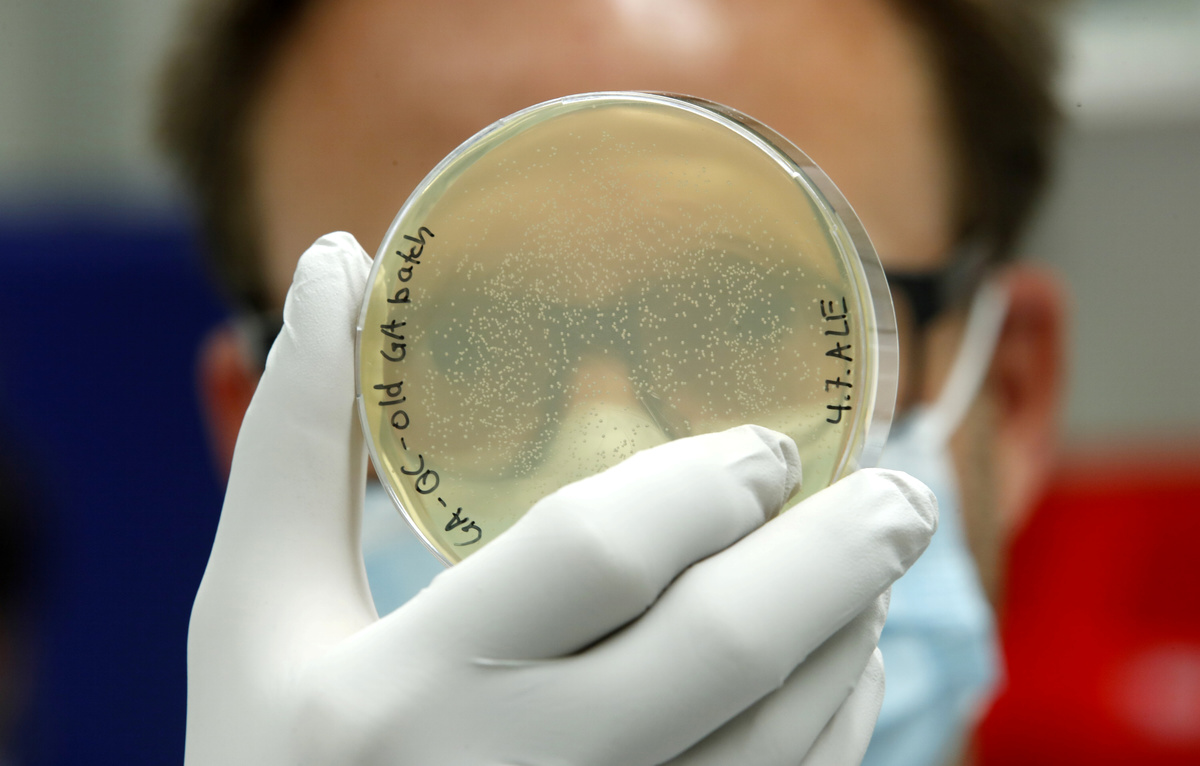

Molecular Partners is getting a payment in the "high single digit millions" of Swiss francs from the Swiss government to reserve doses of an early-stage drug candidate that the Zurich-area biotechnology company is developing for COVID-19.
Fresh off the failure of its eye drug abicipar in the United States, Molecular Partners is seeking to rebound with the experimental drug, called MP0420, against COVID-19.

The Swiss government is upping efforts against the new coronavirus, having last week struck an early access deal for a potential vaccine from U.S.-based Moderna that has entered large trials.
Molecular Partners' drug has yet to start clinical trials, with the company saying it hopes to initiate those later this year.
"The initial supply agreement secures the right to purchase 200,000 doses, with the potential to purchase up to an additional 3 million doses," Molecular Partners said on Tuesday.
The Swiss company was hammered by bad news in June, when abicipar -- in a partnership with U.S. drugmaker AbbVie -- failed to win U.S. Food and Drug Administration approval for blindness causing macular degeneration. The company promptly did a capital increase to shore up its finances.
(Reporting by John Miller; Editing by Jacqueline Wong and Michael Shields)

